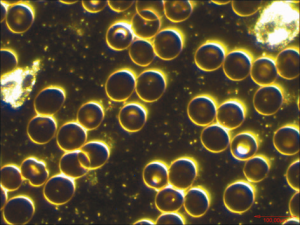

Dunkelfeld Mikroskopie
Informationen zur Vitalblut-Untersuchung im Dunkelfeldmikroskop
Informationen zur Vitalblut-Untersuchung im Dunkelfeldmikroskop
und der radionischen Testung
im Gesundheitszentrum in Ostin
Die Dunkelfeldmikroskopie ist (im Gegensatz zur normalen Untersuchung mit dem Licht-mikroskop/Hellfeld) eine Betrachtung und Einschätzung der Qualität des lebenden / nativen Blutes. Entnommen wird hierzu ein Tropfen aus der Fingerbeere.
Da Dreiviertel unseres Körpers von Flüssigkeit gebildet werden, können wir mit dieser Methode – der Betrachtung einer, den gesamten Organismus durchfließenden Körperflüssigkeit – den Zustand des Organismus zu einem ganz erheblichen Teil beurteilen.
Vor allem erkennen wir das Milieu, das jede Zelle umgibt und die Grundlage für die Gesundheit (bzw. Krankheit) unserer Organe und Organsysteme bildet.
Die Dunkelfelduntersuchung ist eine qualitative Beurteilung des Blutes, keine Messung oder Zählung der Bestandteile – wir kontrollieren also nicht, wie viele weiße Blutkörperchen zum Beispiel vorhanden sind, sondern in welchem Zustand sie sich befinden, wie sie ihre Tätigkeit ausüben, ob sie (von kleinsten Parasiten) befallen sind oder im Übermaß bereits zerfallen.
Durch die lange Erfahrung mit dieser Methode sind Rückschlüsse auf die Ursachen möglich, die eine Milieuveränderung im Blut hervorgerufen haben, die ihrerseits wieder zu den verschiedensten organischen Krankheiten geführt haben oder unbehandelt führen könnten.
Beispielsweise lassen sich u.a. Candidapilze nachweisen, die im Blut in einer getarnten Form auftreten – nicht als die bekannten Hefepilze. Wir bezeichnen sie als C-Candida, da sie „C“= camoufliert, d.h. getarnt sind. Diese neuen Candidaarten finden wir bei 96% aller Patienten jeder Altersgruppe.
Auch C-Trichomonaden (kleinste Parasiten) sind sehr gut nachweisbar – wir finden sie bei ca. 90% der Patienten. Beide führen durch ihren sauren Stoffwechsel zu einer Azidose (Übersäuerung), wodurch das Blutmilieu geschädigt wird und es zu so genannten Sekundärerkrankungen kommen kann.
Des Weiteren lassen sich Borrelien, getarnte „C“-Borrelien sowie M-Borrelien (mutierte Formen) im Blut erkennen, welche nach 2-3 Tagen (während des Zerfallsprozesses) ihren Wirt (z.B. Trichomonaden, Erythrozyten, oa.) verlassen. Unter dem Dunkelfeldmikroskop werden diese Bakterien aufgrund ihrer eigentümlichen Bewegung direkt identifiziert, nicht „nur“ wie bei der herkömmlichen Blutuntersuchung der Antikörpertiter analysiert.
Die mikroskopische Untersuchung findet zunächst am Tag der Blutabnahme zusammen mit dem Patienten statt – das Mikroskopbild wird auf einen Monitor übertragen und die vorhandenen Belastungen werden gezeigt und erklärt. Im Weiteren wird das Blut täglich bis zum vollständigen Zerfall beobachtet – dies dauert idR. 4-5 Tage. Hieraus ergeben sich ggf. zusätzliche therapierelevante Erkenntnisse, die in den Behandlungsplan einfließen.
Zusätzlich wird anhand Ihres Blutes eine radionische Testung vorgenommen – ein bioenergetisches Testverfahren – bei welcher Belastungen des Organismus auf einer Skala von 0 – 10 festgestellt werden. Ihr Blut wird auf Belastungen getestet, die erfahrungsgemäß häufig bei chronischen Erkrankungen beteiligt sind und oft die Wirksamkeit bereits angewandter Heilmittel blockieren: z.B. Quecksilber (in den Zellen und im Bindegewebe), C-Borrelien, Epstein-Barr-Virus und andere.
Des Weiteren testen wir Ihren Vitalitätsstatus.
Wir sehen unsere Aufgabe darin, alle Belastungen Ihres Blutes und der Zellen aufzuspüren und Ihnen über die passende Therapie zu einem gesunden Blutmilieu und damit zu innerer und äußerer Harmonie und Wohlbefinden zu verhelfen.
Bei Rückfragen stehen wir Ihnen jederzeit telefonisch oder auch über e-mail zur Verfügung. Vereinbaren Sie gerne einen Termin mit uns.
Heilpraxis Achim Schulz-Pillgram (HP) im Gesundheitszentrum in Ostin ~ Neureuthstrasse 6 ~ 83703 Gmund am Tegernsee ~ Tel. 08022 864 76 79 ~ info@gesundheitszentrum-in-ostin.de ~ www.gesundheitszentrum-in-ostin.de ~
